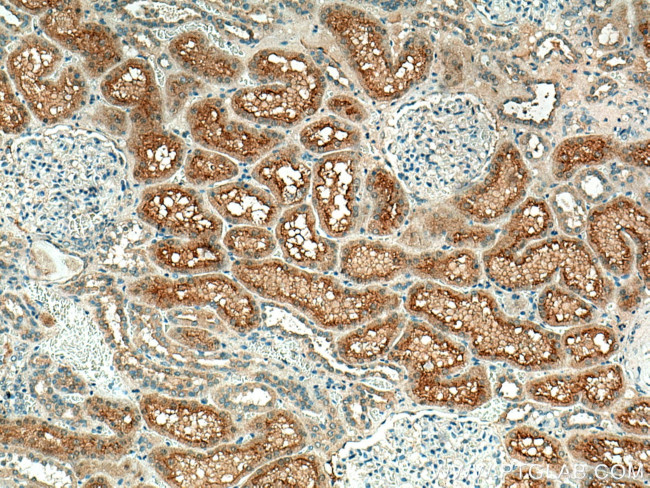
Syntaxin 3 Antibody in Immunohistochemistry (Paraffin) (IHC (P))

Search
Proteintech
Syntaxin 3 Polyclonal Antibody
{{$productOrderCtrl.translations['antibody.pdp.commerceCard.promotion.promotions']}}
{{$productOrderCtrl.translations['antibody.pdp.commerceCard.promotion.viewpromo']}}
{{$productOrderCtrl.translations['antibody.pdp.commerceCard.promotion.promocode']}}: {{promo.promoCode}} {{promo.promoTitle}} {{promo.promoDescription}}. {{$productOrderCtrl.translations['antibody.pdp.commerceCard.promotion.learnmore']}}
产品信息
15556-1-AP
种属反应
已发表种属
宿主/亚型
分类
类型
抗原
偶联物
形式
浓度
规格
纯化类型
保存液
内含物
保存条件
运输条件
产品详细信息
Immunogen sequence: MKDRLEQLK AKQLTQDDDT DAVEIAIDNT AFMDEFFSEI EETRLNIDKI SEHVEEAKKL YSIILSAPIP EPKTKDDLEQ LTTEIKKRAN NVRNKLKSME KHIEEDEVRS SADLRIRKSQ HSVLSRKFVE VMTKYNEAQV DFRERSKGRI QRQLEITGKK TTDEELEEML ESGNPAIFTS GIIDSQISKQ ALSEIEGRHK DIVRLESSIK ELHDMFMDIA MLVENQGEML DNIELNVMHT VDHVEKARDE TKKAVKYQSQ ARKKL (1-264 aa encoded by BC007405)
靶标信息
The gene is a member of the syntaxin family. The encoded protein is targeted to the apical membrane of epithelial cells where it forms clusters and is important in establishing and maintaining polarity necessary for protein trafficking involving vesicle fusion and exocytosis. Alternative splicing results in multiple transcript variants.
仅用于科研。不用于诊断过程。未经明确授权不得转售。
生物信息学
蛋白别名: retina-specific SNARE protein; syntaxin 3A; syntaxin 3B; Syntaxin-3; unnamed protein product
基因别名: DIAR12; MVID2; RDMVID; STX3; STX3A; Syn-3
UniProt ID: (Human) Q13277, (Mouse) Q64704, (Rat) Q08849
Entrez Gene ID: (Human) 6809, (Mouse) 20908, (Rat) 81802